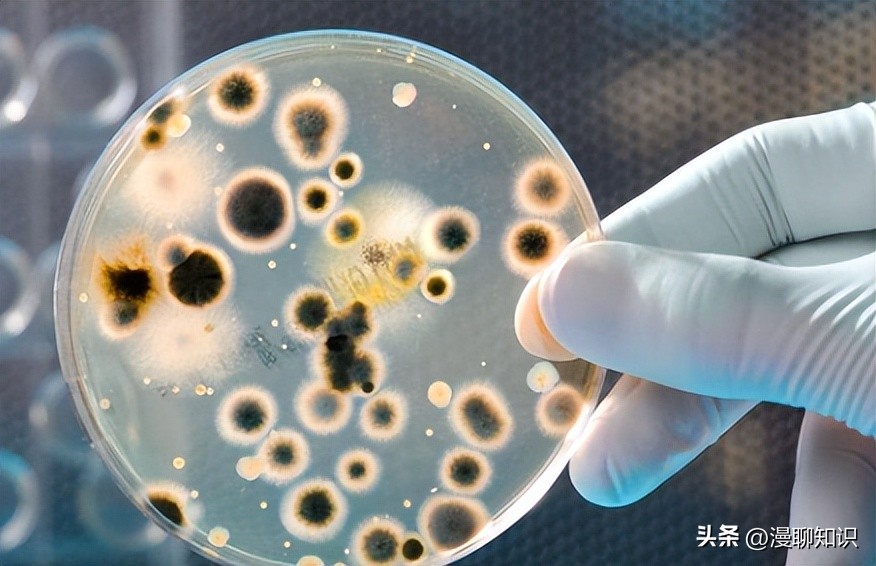
马疱疹病毒感染用什么治疗好,马病毒性疱疹
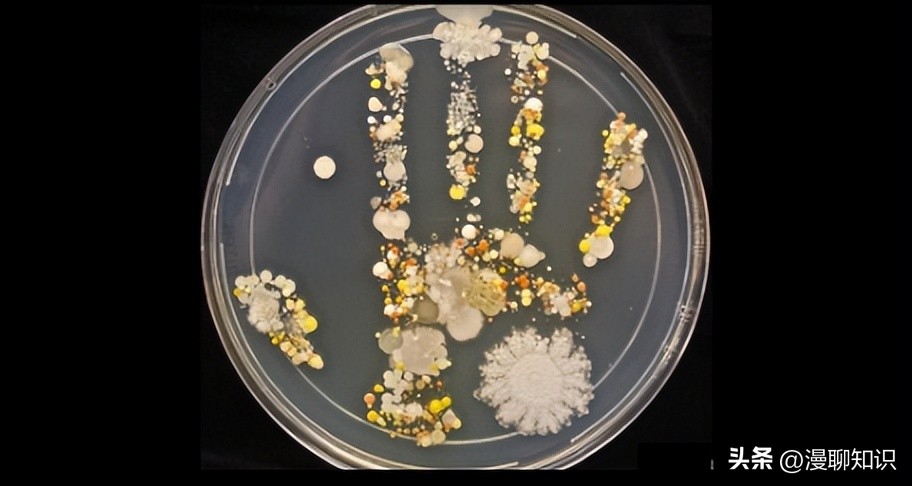
马疱疹病毒感染用什么治疗好,马病毒性疱疹

阅读文章前,辛苦您点下右上角的“关注”,方便您讨论分享,持续关注每日优质内容~
马疱疹病毒(equine herpesvirus,EHV)属于疱疹病毒科马疱疹病毒属,是一种有囊膜的双链DNA病毒。
目前已知的EHV有9种,包括EHV-1~9。
其中,EHV-2又叫马细胞巨化病毒,是γ疱疹病毒亚科蛛猴疱疹病毒属的重要成员。
EHV-2在临床上常引起免疫抑制以及咽炎、肺炎和淋巴结肿大等。
EHV-2在马体内长期呈潜伏感染状态,难以根除,当机体处于应激与高压状态时,可导致反复发烧、流产,也可继发其他疾病。
EHV-2潜伏感染的特性,致感染动物反复发病,久治不愈,给马场以及马血清制品生产企业造成了严重经济损失。
EHV-2在全世界范围内流行,但国内对此研究较少,其流行情况仍不清楚,且未研制出商品化疫苗,这给该病防控带来较大挑战。
本文围绕EHV-2感染的病原学、流行病学、临床表现、检测技术等方面进行综述,以期为后续研究提供参考。

病原学
EHV-2基因组全长约184 kb,G+C含量约为57.7%,共有79个开放阅读框,编码77种蛋白,其中部分蛋白与真核细胞的蛋白有着较高的同源性。
构成EHV-2主要囊膜蛋白的编码基因有g B、TK、g H、g M、g L和g N,其中g B为病毒增殖必需的基因,它表达的免疫原性蛋白可直接参与病毒入侵细胞和细胞间传播的过程。
g B不仅重要,而且表达出的囊膜蛋白保守性最高,因此常被用于病毒鉴定以及遗传变异分析。
通过DNAstar软件对EHV-2、EHV-1和EHV-4的g B基因序列进行比对,结果发现EHV-2与EHV-1、EHV-4的同源性分别为46.1%和44.0%。

流行病学特点
EHV-2分布广泛,在世界各地呈地方性流行,马是其自然宿主。
EHV-2可通过污染的食物、水源、环境以及带毒动物的呼吸道分泌物等进行水平传播,也可以通过胎盘进行垂直传播。
该病毒感染没有部位特异性,在呼吸道、生殖道、眼结膜、乳腺、脑、肺脏、肾脏、脾脏和骨髓中都有被检测到的报道。
在脾脏中,B细胞、巨噬细胞和树突状细胞都能携带潜伏的病毒,而在血液和肺脏中B细胞是主要携带潜伏病毒的细胞。
国外流行情况
EHV-2最初于1963年从患呼吸系统疾病的马身上被分离到,此后在埃塞俄比亚、韩国、美国、波兰及瑞士等多个国家被陆续报道,表明EHV-2已在全球范围内传播。
2017年,Negussie等在非洲埃塞俄比亚北部一个EHV-1高发地区随机采集了160匹有呼吸道症状、111匹临床健康马和驴的血液及鼻拭子样品,经PCR检测发现马EHV-2核酸阳性率为20%。
2019年,为确定临床健康母马生殖道拭子中EHV-2的阳性率,Lee等在韩国采集了430匹临床健康母马的阴道拭子,经PCR检测发现马EHV-2核酸阳性率为2.3%。
2022年,Pusterla等在美国加利福尼亚州患有严重呼吸系统疾病的马鼻拭子与环境拭子中也检测到EHV-2。

国内流行情况
2021年,张磊等首次从*疆新**地区马匹中检测到EHV-2,在健康马及患有呼吸道症状的马鼻拭子中均检测到EHV-2;2022年,帕丽旦·努尔兰等从*疆新**地区马流产胎儿样品中也检测到EHV-2,发现其与波兰、英国及瑞士参考株处于同一进化分支,而与2021年引起呼吸道疾病的EHV-2参考株处于不同进化分支。
以上表明*疆新**地区有两种EHV-2流行,可分别引起马流产和呼吸道疾病。
由于国内EHV-2近几年才被发现,因此其流行情况尚不清楚。
从*疆新**地区发现的两种EHV-2流行株与国外毒株亲缘关系较近,表明国内EHV-2可能是通过边境及进出口贸易传入,或已波及多个边境地区。

临床症状
EHV-2感染常引起呼吸系统病、淋巴结病、眼病、免疫抑制以及流产,动物感染发病时表现为发热、食欲不振、淋巴结肿大、免疫功能低下、结膜炎以及共济失调[。
EHV-2具有潜伏感染的特性,常导致宿主的持续感染,马匹在首次感染后会终身带毒,当机体处于高压、应激或免疫低下状态时,EHV-2会被重新激活,引起马匹发病。
而在不表现明显临床症状时,带毒马匹会通过呼吸道分泌物将病毒传播给健康马匹,导致马群出现EHV-2高阳性率。
目前EHV-2的致病机理仍不清楚。

检测技术
EHV-2具有潜伏感染特点,因而根据临床表现无法做出正确诊断,需要通过实验室检测进行确诊。
国内外已经建立了多种EHV-2检测方法,目前临床检测以PCR方法为主。
病原学检测
病原学检测主要是病原分离鉴定。
临床上常采集患病马鼻拭子或脾脏、肺脏、肾脏等组织样品进行病毒分离。
组织样品经过处理后可得到含有EHV-2的病毒液,将病毒液接种到马胎肾细胞上即可分离到病毒。
EHV-2在马胎肾细胞培养物上能形成典型的细胞病变,如细胞变圆和膨胀,并形成一些合胞体。
经布恩氏液固定,苏木精和伊红染色后形成了A型核内包涵体。
每个小的嗜酸性包涵体都被一个清晰的光晕所包围,倾向于出现在染色更深的位于中央的包涵体之前。

EHV-2典型细胞病变
1963年,Plummer等首次从一匹患有黏膜炎的马身上分离到了EHV-2。
2008年Vengust等从一匹出现吞咽困难、流涎、发热、口腔黏膜脓疱和食管溃疡症状小马的口腔溃疡拭子和血液中分离出EHV-2。
为了提高EHV-2分离效果,Onasanya等在马胎肾细胞的基础上,铺了一层外周血单核细胞用以分离EHV-2。
虽然病毒病原分离鉴定是实验室诊断EHV-2感染的金标准,但病毒分离培养需要花费大量时间,步骤繁琐,分离成功率低,需要较好的实验室条件与技术手段。
近年来,美国国家生物技术信息中心(National Center for Biotechnology Information,NCBI)发表的EHV-2毒株序列较多,冰岛、美国、英国、澳大利亚、中国均发表了不同毒株的序列,但是成功分离到病毒的报道罕见。
免疫学检测技术
血清中和试验
血清中和试验是指在体外适当条件下孵育病毒与特异性抗体的混合物,使病毒与抗体相互反应,再将混合物接种到敏感的宿主(兔等)体内,然后测定残存病毒感染力的一种方法。
Vengust等采集患病马急性期和恢复期血清样本进行中和试验,以1:24的比例稀释血清,在稀释的血清中检测到了EHV-2抗体。
血清中和试验具有较强的特异性和敏感性,是检测动物体内EHV-2抗体水平的标准方法,一直是世界动物卫生组织(WOAH)指定的最常用检测技术,也是最终的验证手段,也常用于评估新建立的检测技术。
开展中和试验需要标准病毒和标准血清样品,二者均没有商品化的产品可以获得,因此也限制了该方法的应用范围。

目前,我国急需EHV-2病毒及其阳性血清标准样品,用于相关检测技术的研发。
4.2.2酶联免疫吸附试验(ELISA)ELISA可用于血清中的EHV-2抗体检测。
Nordengrahn等基于一种具有中和活性的单克隆抗体建立了阻断ELISA方法,用以检测马属动物血清中的EHV-2抗体。
研究人员用该方法检测了2个马场的马血清,其中呼吸道疾病病史的94份血清中,EHV-2阳性率为81%,无呼吸道疾病病史马的EHV-2阳性率为34%;随机抽取91份血清分别进行阻断ELISA和病毒中和试验(virus neutralization test,VNT),结果两种方法的检测结果符合率较高。
ELISA方法可以检测到动物机体在感染早期产生的抗体,敏感性较高,特异性为100%。
张磊等用ELISA方法检测了采自*疆新**乌鲁木齐、昌吉和伊犁等地的血清样品共234份,结果EHV-2、EHV-4和EHV-5阳性率分别为11.1%、5.1%和16.7%。
由于ELISA操作简便、耗时短,可用于大规模的样品筛选检测,因此应用范围更广;同时ELISA方法敏感性高,可能会出现“假阳性”的结果,虽然可以作为一种初筛的方法,但进一步的确定还需要采用中和试验。
目前,国内外ELISA方法的报道较少,仍没有商品化的检测试剂盒,主要依赖于实验室建立的检测方法开展相关研究。

分子生物学检测方法
巢式PCR (nested polymerase chain reaction)
巢式PCR利用两对PCR引物扩增DN*片A**段,第一对PCR引物扩增片段和普通PCR相似,第二对引物称为巢式引物,结合在第一次PCR产物内部,使得第二次PCR扩增片段短于第一次扩增片段来完成检测。
它是第一个用于检测EHV-2的分子生物学工具。
Borchers等基于EcoRI-N基因组片段建立了特异性套式PCR,敏感性高,可用于快速检测EHV-2。
Dall等基于EHV-1、EHV-2、EHV-4和EHV-5 gB基因设计特异性引物建立了多重巢式PCR,可同时检测EHV-1、EHV-2、EHV-4和EHV-5。

Akkutay等在Borchers的基础上设计针对EHV-2和EHV-5 gB基因的特异性引物,并且改进了反应条件,可用于检测血液、鼻拭子样本,诊断由EHV-2和EHV-5导致的混合感染。
巢式PCR的优点在于提高了PCR反应的特异性与敏感性。
多重巢式PCR还可用于诊断由EHV-2和EHV-5导致的混合感染。
但巢式PCR的缺点也较为明显,需要将第一轮扩增产物作为模板进行第二轮扩增,这使得操作过程繁琐,容易造成污染,且需要将PCR产物进行凝胶电泳,耗时较长,因此目前该方法的应用较少。

普通PCR(PCR)
PCR是针对目标基因序列设计特异性引物,扩增目的基因的一种检测方法。
Diallo等针对EHV-2 gB基因设计特异性引物,建立了PCR方法,可对EHV-2感染进行快速诊断。
朱来华等基于EHV-1、EHV-2以及EHV-4 gB基因设计特异性引物建立了多重PCR方法,可在同一反应系统内区分EHV-1、EHV-2以及EHV-4。
普通PCR检测方法程序简单、敏感性高、特异性强,减少了巢式PCR导致的污染,能够将微量的DNA大幅增加,因此能够检测出处于隐性感染或亚临床状态的动物。
除此之外,巢式PCR还具有耗时短,操作简便的特点,适用于大规模筛查。
但PCR方法无法对样品中病毒含量进行定量,而且PCR扩增产物需要电泳观察,耗时较长,现已逐渐被实时荧光定量PCR技术取代。

实时荧光定量PCR(qPCR)
qPCR是在普通PCR技术基础上发展起来的能够实时监测PCR反应进程,对核酸准确定量的技术。
该技术最早由美国Applied Biosystems公司推出,在PCR体系中加入荧光染料或荧光标记的特异性探针,通过实时检测荧光信号变化,分析目标序列拷贝数,结合已知量标准品对靶序列定量。
Hue等首次利用Taq Man技术选取EHV-2的g B基因建立了qPCR方法,敏感性为96%,特异性为95%;Osińska等针对IL-10基因高度保守的区域设计了引物和探针,建立了q PCR方法。
张磊等选取了EHV-2最保守的g B基因建立了SYBR Green q PCR方法,可实现临床样品的实时定量分析,且无需设计和优化探针,提高了检测效率。
该方法能检测到比普通PCR更低病毒载量的样品,在临床样品的检测方面具有更高的敏感性。

Furer等选取EHV-2的gH基因和EHV-5的E11基因设计特异性引物与探针建立了检测EHV-2和EHV-5的双重qPCR,特异性更高,适用于临床上EHV-2与EHV-5的快速鉴别诊断。
在隐性感染状态下,普通PCR检测常呈假阴性结果,而荧光定量PCR技术对处于潜伏感染或亚临床的患病动物进行检测时阳性检出率更高。
除此之外,荧光定量PCR避免了普通PCR敏感性低、操作繁琐、扩增后需电泳以及不能定量分析等缺点,因此被广泛应用。

随着经济的发展,我国马产业发展迅速,规模化养殖场逐渐兴起,马传染病的流行打破了人们对马不易得病的认知。
人们往往重视与经济价值直接相关的马疫病,如马流感、马流产等,而忽略了EHV-2潜伏感染带来的间接经济损失。
EHV-2感染与呼吸系统疾病、免疫抑制以及流产密切相关,可水平传播也可垂直传播,能引起妊娠母马表现出明显的临床症状或亚临床症状,表明其对养马业存在潜在危害。
因此,需要密切监视EHV-2以及与其他马属动物病原体的混合感染情况,持续跟踪EHV-2流行毒株的遗传变异与流行病学动态变化,及时开发有针对性的疫苗,加强对EHV-2感染的防控,保障养马业健康发展。